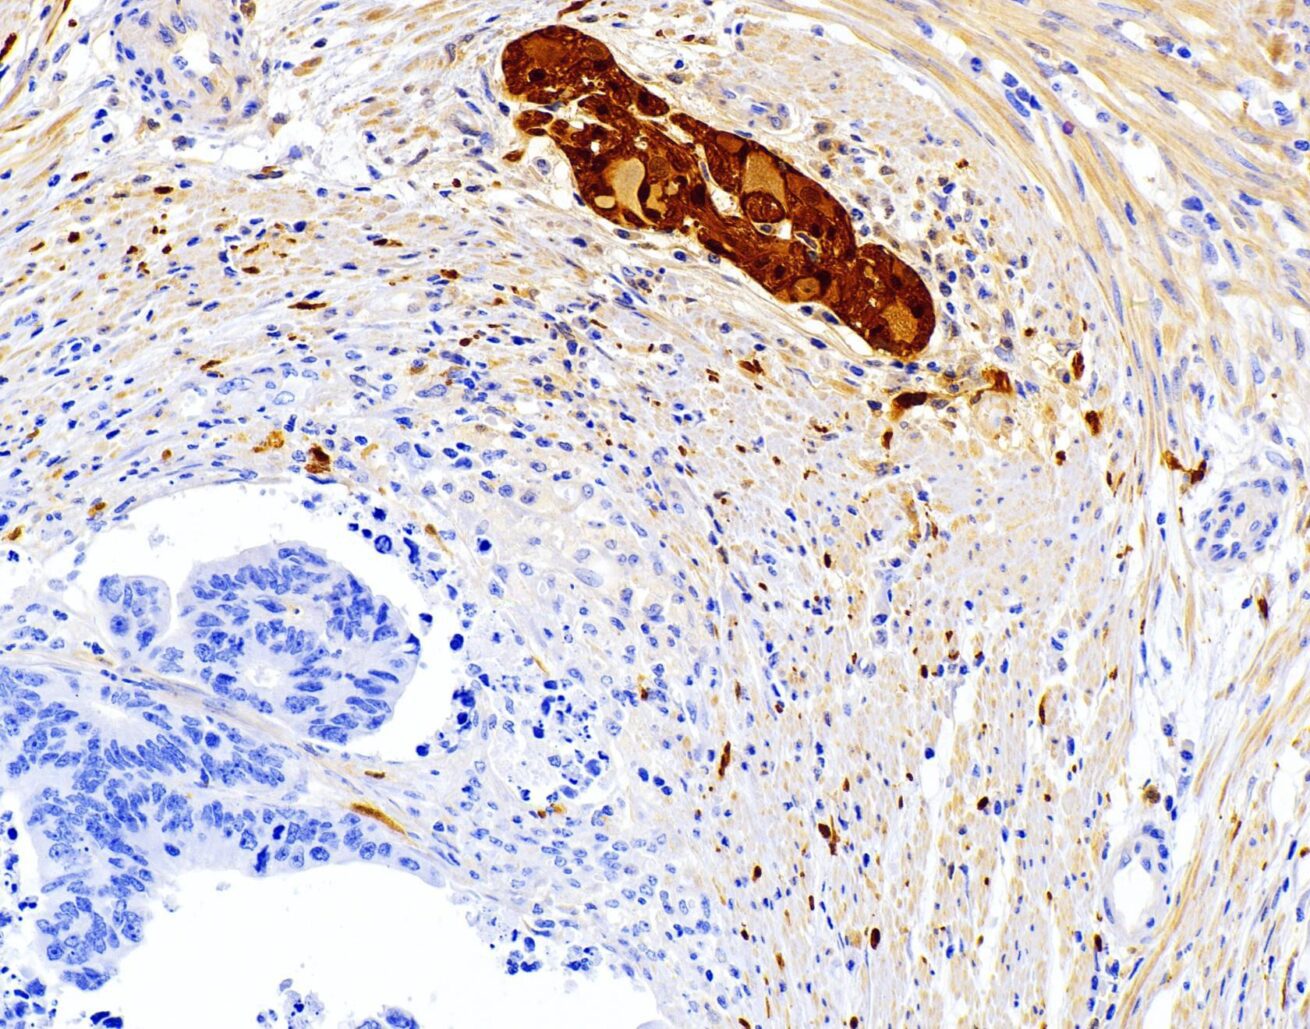
الماسح الضوئي الرقمي للشرائح المرضية: مستقبل التشخيص الطبي؟

لماذا تعتبر منتجات المختبرات السريرية مهمة جدًا؟
الاثنين 03 يونيو 2024
لماذا تعتبر منتجات المختبرات السريرية مهمة جدًا؟ تتطور الرعاية الصحية بسرعة، ولم يكن دور منتجات المختبرات السريرية أكثر أهمية من أي وقت مضى. باعتباري شخصًا متجذرًا في صناعة معدات الرعاية الصحية، أرى بشكل مباشر كيف تؤثر هذه المنتجات على رعاية المرضى والأبحاث والامتثال التنظيمي. تعتبر منتجات المختبرات السريرية ضرورية لأنها تضمن التشخيص
- نشرت في معرفة المنتج
بدون تعليقات
الماسح الضوئي الرقمي للشرائح المرضية: مستقبل التشخيص الطبي؟
الثلاثاء 21 مايو 2024
الماسح الضوئي الرقمي للشرائح المرضية: مستقبل التشخيص الطبي؟ هل تكافح من أجل مواكبة متطلبات التشخيص المرضي الحديث؟ لقد خلق التقدم السريع في التكنولوجيا الطبية حاجة ملحة لحلول فعالة ودقيقة وعالية الإنتاجية في مختبرات علم الأمراض. أدخل ماسح الشرائح المرضية الرقمي - أداة ثورية تغير الطريق
- نشرت في معرفة المنتج
استكشاف دور جداول الفحص النسائي: ما الذي يجعلها ضرورية؟
الاثنين 20 مايو 2024
استكشاف دور جداول فحص أمراض النساء: ما الذي يجعلها ضرورية؟ باعتباري الرئيس التنفيذي لشركة AMIS، الشركة الرائدة في مجال تصنيع معدات المستشفيات، فإنني مفتون دائمًا بالدور المحوري الذي تلعبه طاولات الفحص النسائي في أماكن الرعاية الصحية. في هذه المقالة، سوف نتعمق في الميزات والوظائف الأساسية لهذه الجداول، ونستكشف سبب وجودها
- نشرت في معرفة المنتج
ما مدى أهمية أسرة المستشفيات الكهربائية بالكامل للرعاية الصحية اليوم؟
الأربعاء 15 مايو 2024
ما مدى أهمية أسرة المستشفيات الكهربائية بالكامل للرعاية الصحية اليوم؟ تعد صناعة الرعاية الصحية جبهة حاسمة في مجال الابتكار، وخاصة في تحسين رعاية المرضى والكفاءة التشغيلية. وفي قلب هذا الابتكار يوجد سرير المستشفى الكهربائي بالكامل، وهو حجر الزاوية في الرعاية الطبية الحديثة. في AMIS، حيث نحن متخصصون في تصنيع معدات المستشفيات عالية الجودة،
- نشرت في معرفة المنتج
لماذا لا غنى عن الكي الكهربائي في الممارسات الجراحية الحديثة؟
الجمعة 10 مايو 2024
لماذا لا غنى عن الكي الكهربائي في الممارسات الجراحية الحديثة؟ باعتباري الرئيس التنفيذي لشركة AMIS، وهو مصنع رائد في إنتاج معدات المستشفيات، فأنا على اتصال دائم بأحدث الابتكارات التي تعمل على تحسين النتائج الجراحية بشكل كبير. ومن بين هذه الأدوات، يبرز الكي الكهربائي كأداة لا غنى عنها في الطب الحديث. تستخدم هذه الطريقة أدوات يتم تسخينها كهربائيًا،
- نشرت في معرفة المنتج
ما مدى أهمية أسرة المستشفيات المنزلية الكهربائية للحصول على رعاية منزلية عالية الجودة؟
الخميس 09 مايو 2024
ما مدى أهمية أسرة المستشفيات المنزلية الكهربائية للحصول على رعاية منزلية عالية الجودة؟ قد تكون مواجهة تعقيدات الرعاية المنزلية أمرًا شاقًا، ولكن في AMIS، نسعى جاهدين لتبسيط هذه التجربة. إن أسرة المستشفيات المنزلية الكهربائية لدينا ليست مجرد قطعة من المعدات؛ إنهم حجر الزاوية في الرعاية الصحية المنزلية الفعالة، حيث يقدمون الدعم الحاسم للمرضى ومقدمي الرعاية
- نشرت في معرفة المنتج
لماذا تعتبر الموجات فوق الصوتية دوبلر حاسمة في مراقبة الحمل؟
الإثنين، 06 مايو 2024
لماذا تعتبر الموجات فوق الصوتية دوبلر حاسمة في مراقبة الحمل؟ في AMIS، نحن نفخر بفهمنا العميق لمعدات المستشفيات وتطبيقاتها في السيناريوهات الطبية في العالم الحقيقي. اليوم، أريد أن أناقش أداة أصبحت لا غنى عنها في رعاية ما قبل الولادة: الموجات فوق الصوتية دوبلر. هذا الجهاز لا يضمن فقط صحة وسلامة الحامل
- نشرت في معرفة المنتج
ما الذي يجعل أسرة المستشفيات الكهربائية ضرورية لمنشآت الرعاية الصحية الحديثة؟
الأحد، 05 مايو 2024
ما الذي يجعل أسرة المستشفيات الكهربائية ضرورية لمنشآت الرعاية الصحية الحديثة؟ مع تطور صناعة الرعاية الصحية، يزداد الطلب على حلول رعاية المرضى الأكثر تقدمًا وراحة. أنا ليلي سونج، الرئيس التنفيذي لشركة AMIS، حيث نتخصص في معدات المستشفيات التي تعزز رعاية المرضى وعمليات الرعاية الصحية. أسرة المستشفيات الكهربائية هي حجر الزاوية في منتجاتنا
- نشرت في معرفة المنتج
لماذا تعتبر آلة الموجات فوق الصوتية الطبية ضرورية للطب الحديث؟
الثلاثاء 30 أبريل 2024
لماذا تعتبر آلة الموجات فوق الصوتية الطبية ضرورية للطب الحديث؟ في عالم التكنولوجيا الطبية، هناك عدد قليل من الأدوات التي توفر مزيجًا قويًا من الأمان والتنوع والدقة مثل جهاز الموجات فوق الصوتية الطبية. في AMIS، الشركة الرائدة في مجال تصنيع المعدات الطبية، نحن ملتزمون بتزويد المتخصصين في الرعاية الصحية بأحدث تقنيات الموجات فوق الصوتية للمساعدة في
- نشرت في معرفة المنتج
ما هو اختبار الدوبلر للقلب؟
الجمعة 26 أبريل 2024
ما هو اختبار الدوبلر للقلب؟ عندما يتعلق الأمر بتشخيص أمراض القلب، فإن الدقة والموثوقية هما المفتاح. في AMIS، نحن ندرك أهمية أدوات التشخيص المتقدمة في مجال الرعاية الصحية. يستخدم اختبار دوبلر للقلب، المعروف أيضًا باسم تخطيط صدى القلب دوبلر، موجات صوتية لتقييم حركة الدم عبر قلبك
- نشرت في معرفة المنتج